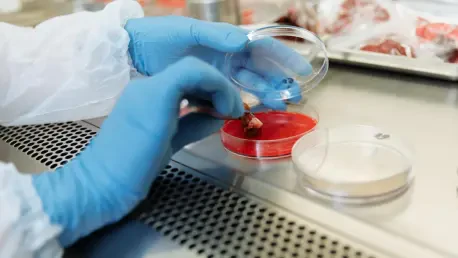
35th Bunshu Medical Award Honors Breakthrough Research

In the ever-evolving landscape of medical science, few recognitions carry the weight and prestige of the 35th Bunshu Medical Award, recently announced by the Korean Medical Association (KMA) and Korea Boehringer Ingelheim in South Korea. Established in 1990, this esteemed award not only celebrates extraordinary achievements in medical research and development but also strengthens academic and professional ties between South Korea and Germany. Named in honor of Dr. Richard Wunsch, the first German physician in Korea who served as the personal doctor to King Gojong of the Joseon Dynasty, it symbolizes a legacy of excellence and cross-cultural collaboration. This year, the spotlight shines on remarkable individuals—Professor Oh Do-yeon, Professor Kim Young-kwang, and Senior Researcher Jin Ho-kyung—whose pioneering contributions are reshaping healthcare standards. Their work exemplifies innovation, addressing critical challenges in oncology, pathology, and neurology with solutions that promise to impact patients globally.
A Tradition of Medical Excellence
The Bunshu Medical Award stands as a beacon of distinction, categorized into two significant divisions: the primary award for seasoned medical scientists with over two decades of transformative contributions to South Korean medicine, and the Young Medical Person Award, which honors researchers under 40 for their exceptional academic advancements. Renowned for its rigorous selection process, this accolade ensures that only the most impactful and dedicated professionals are recognized, solidifying its status as a pinnacle of achievement in the medical field. The upcoming ceremony, set for November 25 at the Plenty Convention in Seoul St. Mary’s Hospital, will serve as a platform to celebrate these outstanding contributions. This event not only highlights individual successes but also reinforces the award’s role in fostering a culture of excellence and innovation within the South Korean medical community, inspiring continued progress and collaboration on a national and international scale.
Beyond the recognition of individual achievements, the Bunshu Medical Award represents a commitment to advancing medical science for the greater good. It bridges generational gaps by honoring both veteran experts and rising stars, ensuring a dynamic flow of ideas and methodologies that keep South Korean medicine at the forefront of global healthcare. The emphasis on both long-term dedication and youthful innovation creates a balanced ecosystem where experience informs fresh perspectives, and emerging talent pushes established boundaries. This dual focus is evident in the diverse fields represented by this year’s recipients, whose work collectively addresses some of the most pressing health issues of the modern era. By bringing such varied expertise under one banner, the award not only celebrates past and present successes but also sets a visionary tone for the future of medical research, encouraging interdisciplinary approaches and international partnerships that amplify impact.
Transforming Cancer Care Through Innovation
Professor Oh Do-yeon from Seoul National University of Medicine has earned the Clinical Division award for his groundbreaking research in gastrointestinal cancers, with a particular focus on biliary tract cancer. His pioneering studies have introduced a novel treatment approach by integrating immuno-oncology with conventional chemotherapy, achieving unprecedented improvements in tumor response rates, progression-free survival, and overall survival for patients. This marks a historic milestone as the first global demonstration of the safety and efficacy of such combination therapy for this specific cancer type. Leading subsequent international Phase 3 trials, Professor Oh has played a pivotal role in establishing new global standards of care, offering renewed hope to countless patients facing limited options. His work underscores the transformative potential of clinical research in addressing critical gaps in cancer treatment, particularly in areas historically overlooked by drug development efforts.
In a parallel stride within cancer research, Professor Kim Young-kwang from Catholic University of Medicine was awarded the Basic Category for developing PEER-seq technology, a cutting-edge method that assesses the functional impacts of cancer-related gene mutations on a massive scale. This innovation has produced detailed profiles of resistance to tyrosine kinase inhibitors in EGFR mutations, a vital aspect of cancer therapy. Furthermore, it provides a unique framework for evaluating drug resistance in variants of uncertain significance, which are genetic mutations with unclear clinical relevance. Such advancements are poised to deepen the understanding of genetic underpinnings in cancer, facilitating the shift toward personalized precision medicine tailored to individual patient profiles. Professor Kim’s contributions highlight how technological breakthroughs can refine diagnostic accuracy and therapeutic strategies, ultimately enhancing treatment outcomes and paving the way for customized healthcare solutions.
Advancing Neurological Care with Non-Invasive Solutions
Senior Researcher Jin Ho-kyung from the Institute of Basic Science has been honored with the Young Medical Person Award in the Clinical Category for his innovative research on cerebrospinal fluid (CSF) discharge pathways. His studies have clarified previously obscure pathways hampered by anatomical complexity, revealing that targeting nasopharyngeal and cervical lymphatic vessels outside the skull can significantly enhance CSF discharge functions. This discovery introduces a non-invasive treatment strategy that sidesteps the inherent risks of brain surgery, presenting a safer and more practical option for clinical application. Recognized for its forward-thinking approach, Jin’s work offers a promising alternative for managing conditions related to CSF dysfunction, prioritizing patient safety and recovery. This breakthrough could redefine treatment methodologies in neurosurgery, making care more accessible and less daunting for those in need.
The implications of Jin’s research extend beyond immediate clinical applications, signaling a broader shift toward minimally invasive techniques in neurological care. By focusing on external lymphatic targets, his findings mitigate the need for highly invasive procedures that often carry significant risks and lengthy recovery periods. This approach not only enhances patient outcomes by reducing potential complications but also aligns with global healthcare trends that emphasize safety and efficiency in medical interventions. Additionally, the potential to adapt these findings to a variety of neurological conditions suggests a versatile framework for future research and treatment development. Jin’s contribution, celebrated through this award, exemplifies how innovative thinking can address longstanding challenges in medicine, offering solutions that are both effective and compassionate, and setting a precedent for future explorations in non-invasive therapeutic strategies.
Global Impact and Collaborative Innovation
A unifying theme among this year’s Bunshu Medical Award recipients is their unwavering commitment to innovation, tackling unmet medical needs with groundbreaking solutions that resonate on a global scale. Professor Oh’s redefinition of cancer treatment protocols has set international benchmarks, while Professor Kim’s genetic profiling technology promises to revolutionize personalized medicine worldwide. Similarly, Researcher Jin’s non-invasive neurological techniques offer universally applicable solutions that prioritize patient safety. Together, their efforts enhance patient outcomes through improved survival rates, tailored therapies, and safer interventions. The collaborative spirit of their work, particularly evident in Professor Oh’s partnerships with multinational pharmaceutical entities, highlights the critical role of global cooperation in amplifying the reach and impact of medical advancements, ensuring that breakthroughs benefit diverse populations.
Moreover, the recognition of these researchers underscores the interconnected nature of modern medical science, where advancements in one field can inspire progress in others. The synergy between clinical application, as seen in Professor Oh’s trials, and foundational research, exemplified by Professor Kim’s technological innovations, demonstrates how varied approaches can converge to address complex health challenges. Researcher Jin’s focus on accessibility further complements this narrative by ensuring that cutting-edge solutions are practical for widespread adoption. This collective impact reflects a broader movement within South Korean medicine to lead on the global stage, fostering an environment where collaboration across borders and disciplines drives meaningful change. The Bunshu Medical Award thus serves as a catalyst for such international dialogue, celebrating achievements that not only solve immediate problems but also lay the groundwork for future healthcare innovations.
Vision for Tomorrow’s Healthcare Landscape
Reflecting on the 35th iteration of this prestigious award, it becomes evident that the honored research aligns with emerging global healthcare trends, such as the push toward precision medicine and non-invasive treatments. The KMA and Korea Boehringer Ingelheim have lauded the recipients for their role in enhancing patient quality of life and elevating South Korea’s prominence in international medical research. Professor Oh’s paradigm-shifting cancer therapies, Professor Kim’s strides in genetic understanding, and Researcher Jin’s safer neurological approaches collectively position South Korean researchers as leaders in these transformative areas. Their work not only addresses current medical challenges but also sets a forward-looking agenda for the evolution of healthcare practices, emphasizing individualized care and patient-centric solutions that are shaping the future of medicine.
The legacy of the Bunshu Medical Award extends beyond mere recognition, acting as a powerful motivator for future generations of medical professionals to pursue innovative research with global implications. By honoring both established experts and emerging talents, it ensures a continuous pipeline of creativity and dedication within the field. The diverse expertise of this year’s awardees serves as a reminder of the multifaceted nature of medical science, where breakthroughs in oncology, pathology, and neurology can inspire cross-disciplinary advancements. As the medical community looks ahead, the contributions of these researchers provide a robust foundation for ongoing progress, encouraging sustained investment in research and translation of findings into clinical practice. Their achievements celebrated at this event mark a significant chapter in the journey toward a healthier world, reinforcing the importance of perseverance, collaboration, and visionary thinking in overcoming the complex health challenges of today and tomorrow.